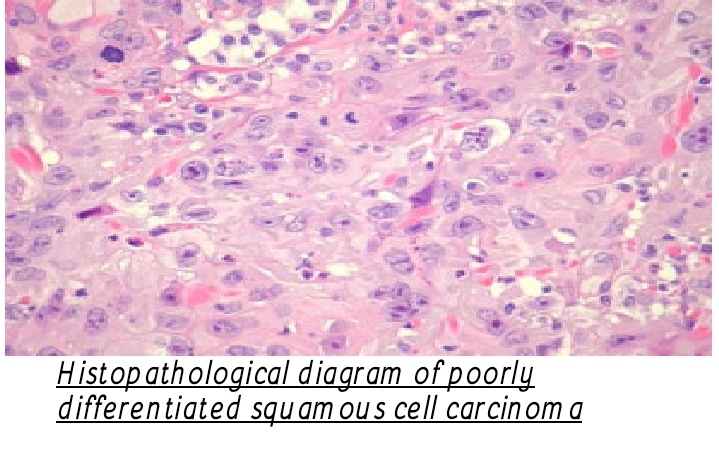

Fibrous dysplasia is a chronic problem in which scar-like tissue grows in place of normal bone. It often results in one or more, of the following: Bone deformity. Brittle bones.

















Fibrous dysplasia is a chronic problem in which scar-like tissue grows in place of normal bone. It often results in one or more, of the following: Bone deformity. Brittle bones.